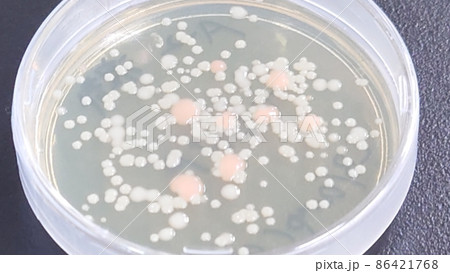
手のひらのばい菌培養シャーレ 手のひらのばい菌培養シャーレ 86421768

手のひらのばい菌培養シャーレ[86421768]の写真素材は、水、手洗い、料理のタグが含まれています。この素材はlassieさん(No.1220897)の作品です。SサイズからLサイズまで、¥550からPIXTA限定でご購入いただけます。無料の会員登録で、カンプ画像のダウンロードや画質の確認、検討中リストをご利用いただけます。 全て表示
手のひらのばい菌培養シャーレ
※PIXTA限定素材とは、PIXTA本体、もしくはPIXTAと提携しているサイトでのみご購入いただける素材です。
拡大・縮小
※ 画像をドラッグすることで移動させることができます
クレジット(作者名表記) : lassie / PIXTA(ピクスタ)
この素材についてもっと見る
- 被写体の権利確認について詳しくはこちら
- アクセス : 441
- 過去の購入 : なし
- この素材についてクリエイターへ問い合わせる
- 販売に不適切な素材として報告